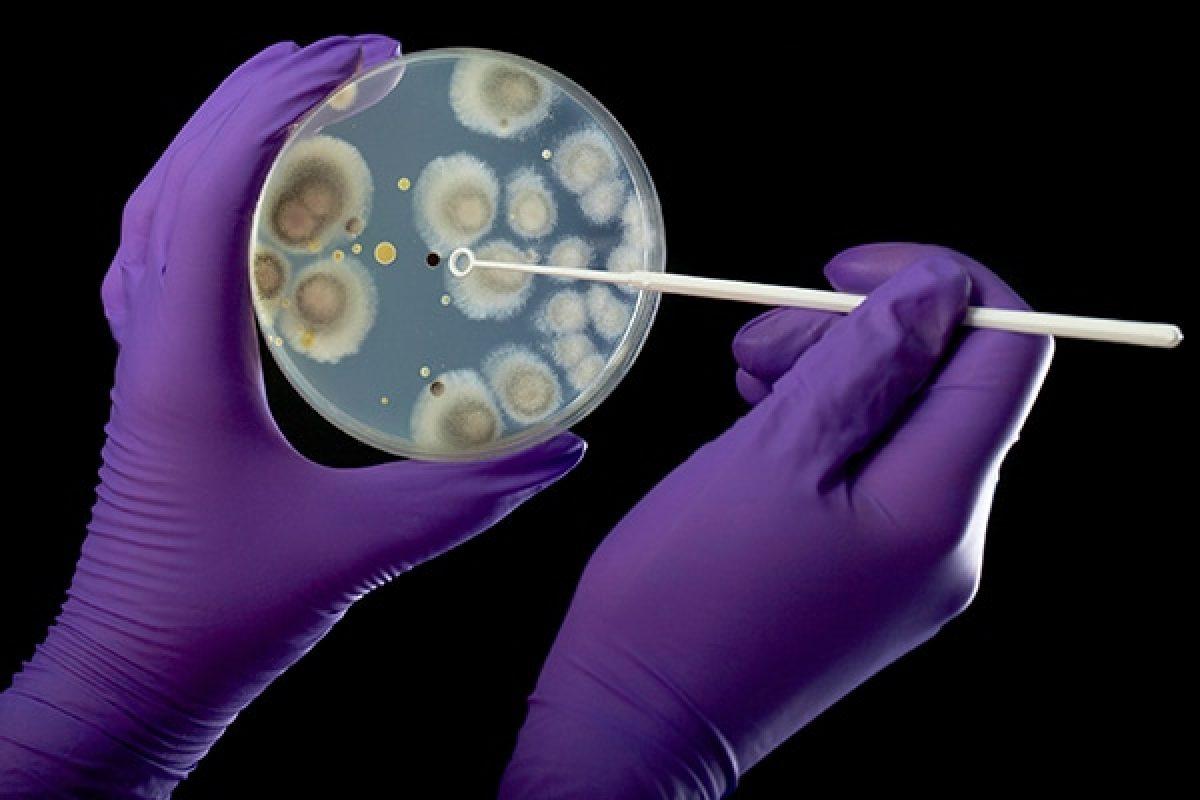

Índice
ALERTAde presunta nueva “pandemia” 3
Carta Consejo Directivo 5
Texto subjetivo 6
¿Por qué es importante comer saludable? 6
Noticia
Nueva pandemia que al parecer podría costarte la vida.
ALERTA
de presunta nueva “pandemia”
El 20 de febrero del presente año, un hombre estadounidense llegó a la emergencia del hospital ‘ DC HOSPITAL’ localizado en la capital estadounidense , este hombre llegó enfermo y un tanto débil, rápido los médicos lo atendieron y por la tarde, en una rueda de prensa, dieron a conocer que apenas lo atendieron se le despegaron las piernas, dicen que quedaron en shock y no sabían que le había pasado, era una enfermedad totalmente desconocida
Los médicos dijeron que se podría tratar de un nuevo virus, rápidamente los científicos empezaron a investigar este caso y dijeron que se podría tratar de un virus pero no estaban 100% seguros, pero el día después llegó una mujer al hospital con los mismos síntomas y vieron que se trataba de este posible “nuevo virus”.
Los científicos han declarado que esto se trata de una pandemia y le pusieron como nombre “NO MORE WALKS” el estado de Washington lo declararon estado de emergencia ya que se han reportado múltiples casos. Los síntomas más comunes son: mucha congestión nasal, dolor de cabeza, una extraña sensación de no sentir las piernas, se te duerme la lengua, empiezas a ver borroso y se te caen las pestañas

Ya el virus se ha expandido por todo el mundo y ya varios países han puesto cuarentena, las calles están solas y la gente tiene miedo y temen por su vida Tengan prevención, quédense en casa, por su salud.
 Gabriela Lucena
Gabriela Lucena
Texto Instruccional
Pasos para el estudio diario del violín: ¿Qué debes hacer?


1- Afine el violín con la App, moviendo cuidadosamente las clavijas y el afinador
2 Estudie las escalas indicadas por su profesor con distintos ritmos, algunos pueden ser negra, blanca, redonda, tresillos, cuartina, entre otros, esto funciona para calentar dedos, manos, y brazos para todo el tiempo de estudio.
3 Divida la primera lección, de un en un pentagrama o de dos en dos.
4 Después debe solfear (cantar) nota por nota en blancas o redondas
5- Estudiar con ritmos combinados como, cuartina, tresillo, galopas, una cuartina un tresillo, ligando dos notas, entre otros combinándolos entre sí
6 Solfear al ritmo que está escrito pero cuidadosamente y lento 7-Tocar como está escrito en blancas para poder analizar todas las notas.
8 Aumentar progresivamente la velocidad, hasta llegar al tiempo real, usando el metrónomo establecido por su profesor
9 Pasar al siguiente pasaje (siguiente pentagrama), solo si lo que se estudio está perfectamente sino, volver a estudiar todos los pasos desde cero 10- Luego de pasar por cada pentagrama, debe estudiarlo todo corrido haciendo las indicaciones de sentimientos escritos, como piano, forte, detache, entre otros 11 Lo último es repetir estos pasos con cada lección, canción, libro, concierto que tengas.
Notas: No dejar pasar errores, siempre buscar la perfeccion
● Cada paso debe tener como mínimo 5 repeticiones que esten excelentes, de no ser así iniciar de nuevo
● Se debe estudiar un mínimo de 4 horas diarias, pueden ser las 4 horas seguidas o 2 horas en la mañana, y 2 horas en la tarde, las horas de estudio deben ser respetadas sin estar con otras cosas como el teléfono, ir al baño u otras excusas.
Carta Consejo Directivo
Barquisimeto, 11 de octubre de 2022. Lic JhoanaAnez
Consejo Directivo Colegio Las Fuentes. Su despacho
Saludos, nos dirigimos a ustedes con el mayor respeto posible para hacerles una solicitud
En esta oportunidad requerimos, si es posible, cambiar o en su defecto arreglar la conexión de internet, ya que se nos dificulta trabajar en nuestras asignaciones que son por medio de páginas web en el aula
Sin más que agregar, esperando su pronta y positiva respuesta, se despide de usted
Atentamente
Gabriela Lucena 32.760.135 Flavia Rodríguez 33 116 763 Estudiantes de 2do año
Gabriela Lucena
Texto subjetivo
qué es importante comer saludable?


Estamos conscientes de que los seres humanos que se alimentan de forma nutritiva, saludable y equilibrada, con alimentos variados nos lleva a desarrollarnos, crecer sanos y fuertes, tener más energía para trabajar hacer los deberes o tareas; sufrir menos infecciones y enfermedades, tener mejor autoestima, y estar en forma, haciendo que en nuestras vidas tengamos buenos resultados, así podremos cumplir nuestras metas y sueños
Para lograrlo puedes proponerte una dieta leve (no estricta) comiendo de meriendas frutas como cambur, manzana, uvas, también podrías agregar cosas saludables a un alimento normal de tu comida diaria, como ejemplo, le agregas a la mezcla que quieras, avena y así con todo lo demás logrando tu objetivo, ayudando a tu salud y estabilidad de vida

¿Por
